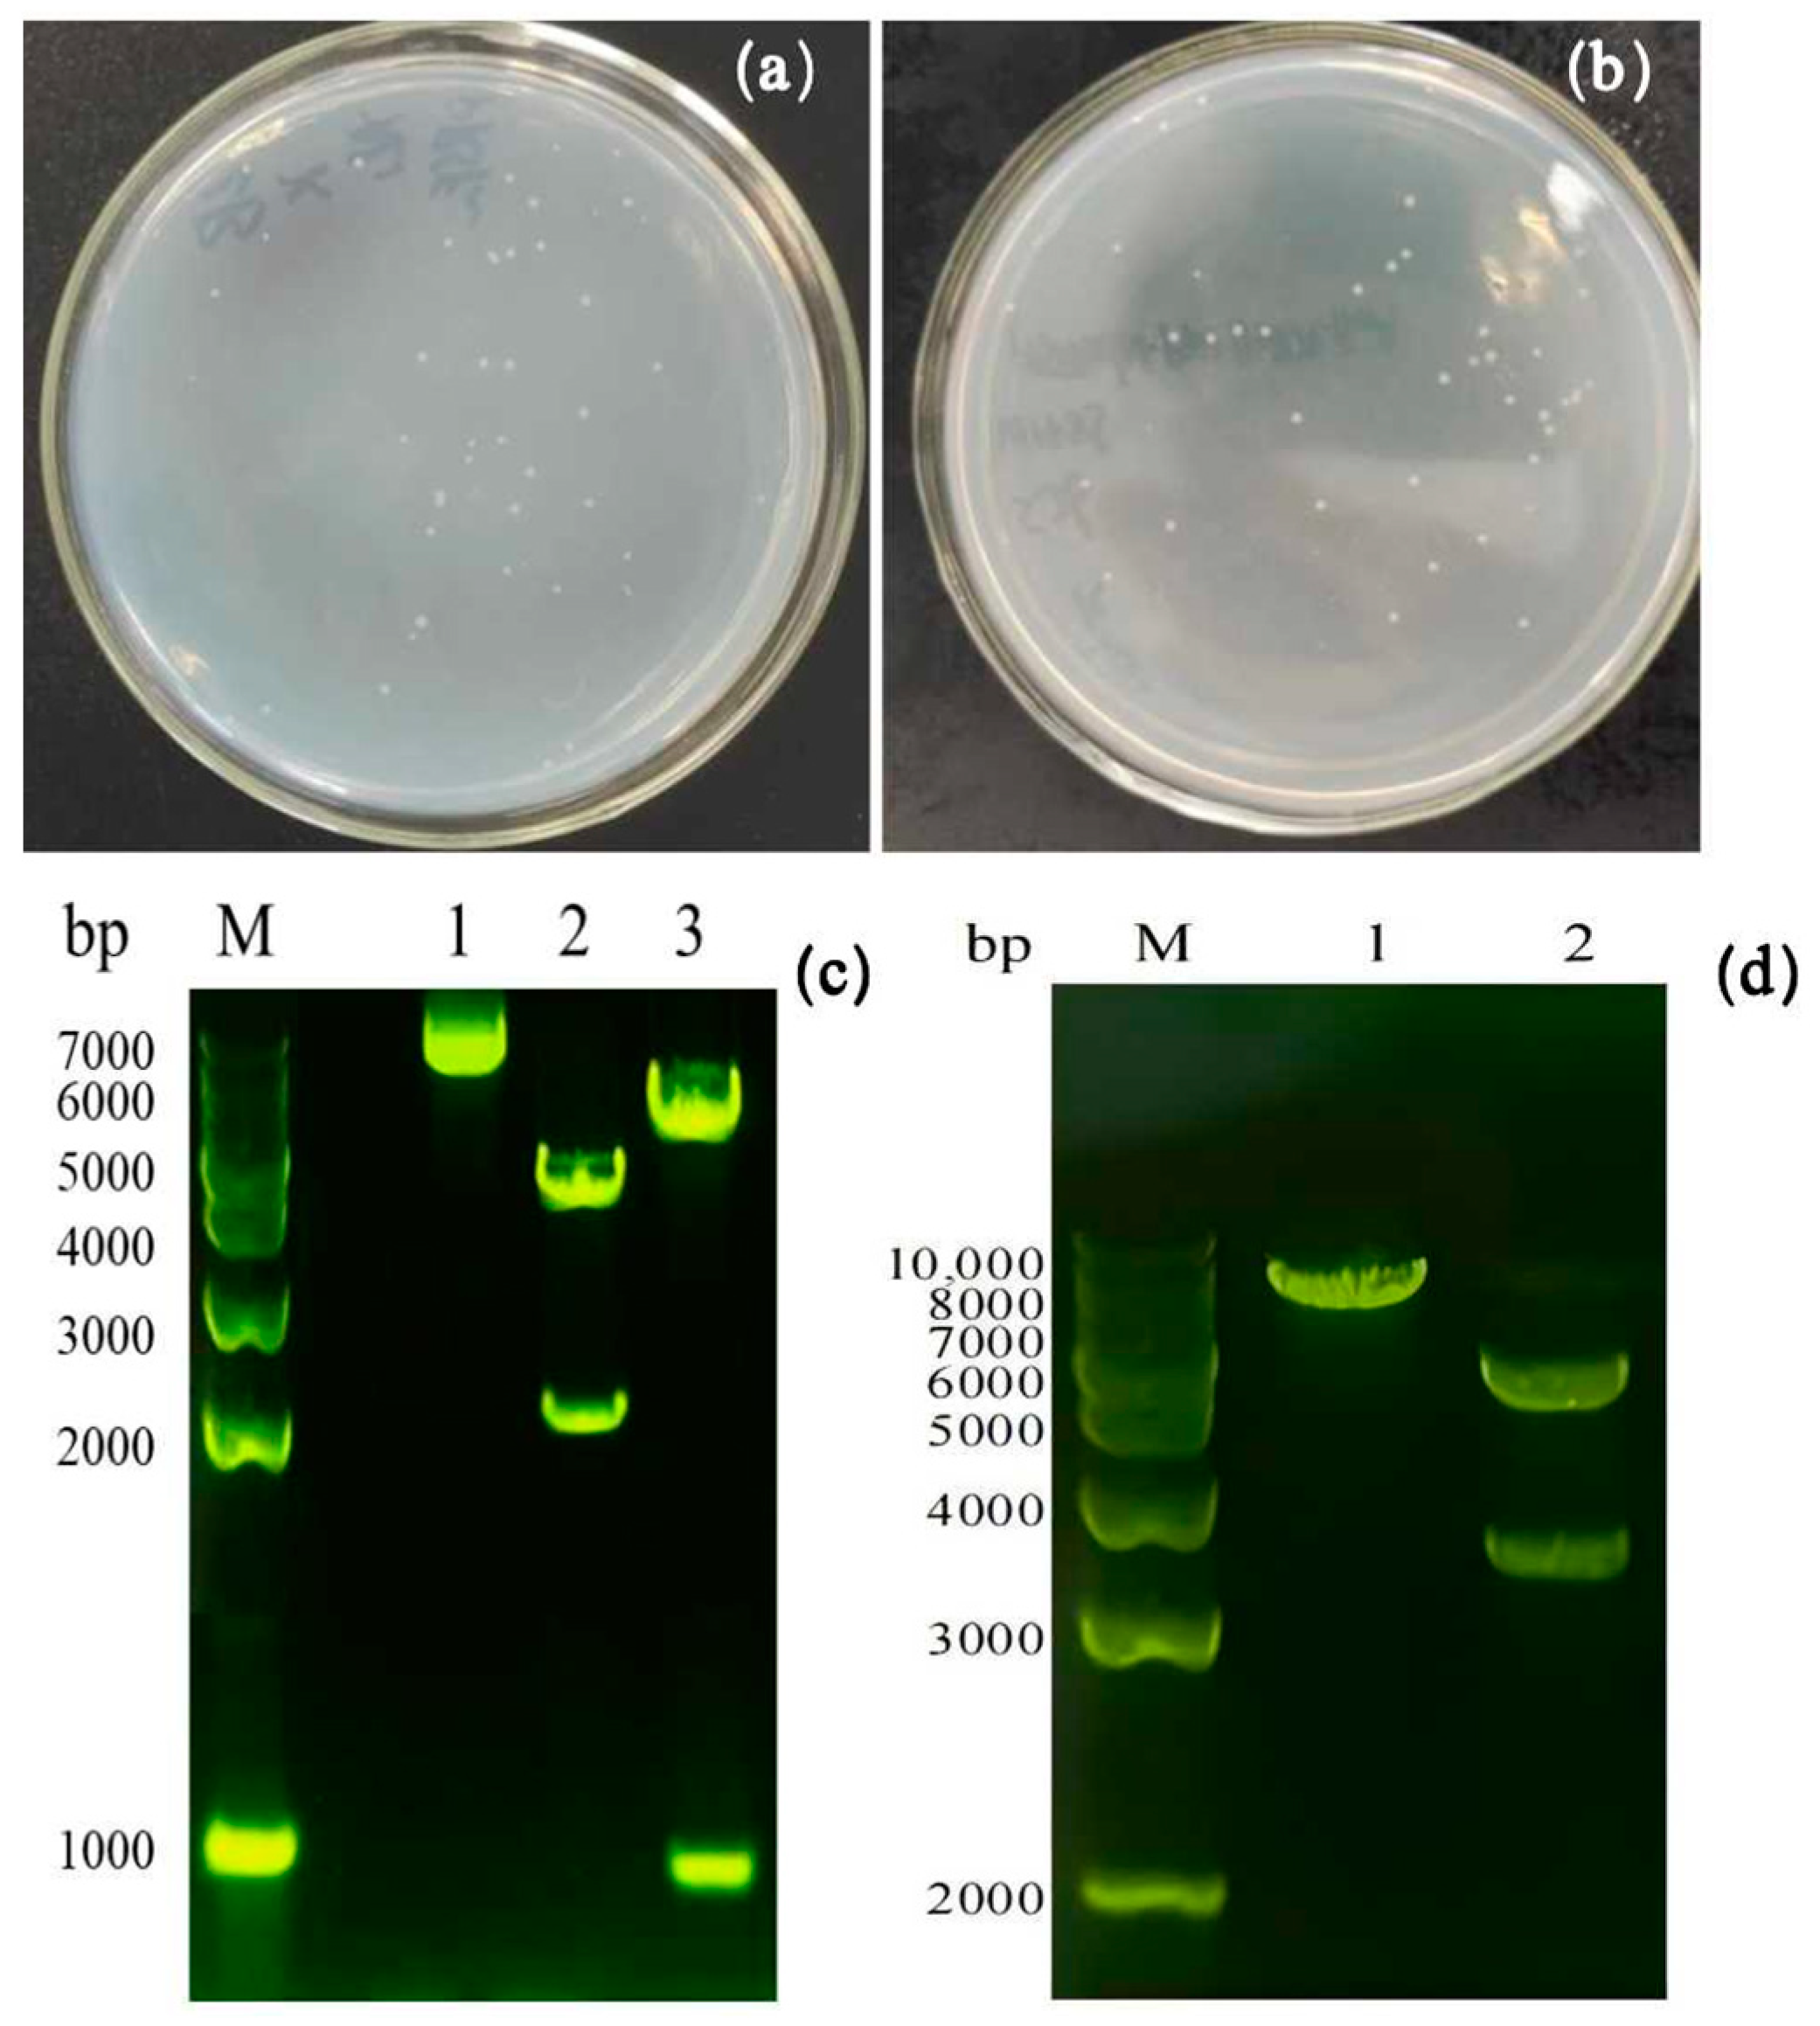

Construction of Trans-4-hydroxy-L-proline-producing Escherichia coli and Optimization of Fermentation Conditions
Abstract
1. Introduction
2. Materials and Methods
2.1. Strains and Plasmids
2.2. Construction of Recombinant Plasmids
2.2.1. Construction of Recombinant Plasmids pRSFDuet-1-p4h-proBA and pET28b-p4h-proBA
2.2.2. Enzymatic Validation of Recombinant Plasmids pRSFDuet-1-p4h-proBA and pET28b-p4h-proBA
2.2.3. Induction Culture of Recombinant E. coli and Protein Expression
2.3. Determination of L-hydroxyproline
2.3.1. Qualitative Determination of L-hydroxyproline by Ninhydrin Thin-Layer Chromatography
2.3.2. Determination of L-hydroxyproline in Fermentation Broth by High Performance Liquid Chromatography
- (1)
- For the 0.1% aqueous phosphoric acid solution, we added 1 mL of phosphoric acid to a 1000 mL volumetric flask, then added water and shook well.
- (2)
- For the 1 mol/L sodium hydroxide solution, we weighed 4.0 g of sodium hydroxide in a 100 mL volumetric flask, dissolved it in water and shook well.
- (3)
- For the standard/sample solution, we accurately weighed 50 mg of standard L-hydroxyproline in a 50 mL volumetric flask (i.e., 1 g/L); it was then dissolved in an appropriate amount of purified water before adding 2 mL of 50% p-nitrobenzyl chloroformate in dichloromethane solution. The solution was shaken vigorously for 15 min, 3 mL of 1 mol/L NaOH was added, it was shaken vigorously again for 10 min, and then purified water was added to fix the volume before setting it aside [19,20,21].
2.4. Determination of Proline-4-Hydroxylase P4H Enzymatic Activity
2.5. Fermentation Conditions for Recombinant E. coli
2.6. Optimization of Fermentation Conditions
3. Results and Discussion
3.1. Transformation of Recombinant Plasmids and Enzymatic Verification of Positivity
3.2. Recombinant E. coli Fermentation Results
3.3. Growth Curve of Recombinant E. coli T7E/pRSFDuet-1-p4h-proB-proA
3.4. Optimization of Fermentation Medium Components
3.5. Optimization of Culture Conditions of Fermentation Medium
3.6. Analysis of Results of Orthogonal Experiments
3.7. Fermentation of Recombinant E. coli
3.8. Changes in Enzyme Activity of Recombinant E. coli Wet Cells After Optimization
3.9. Effect of the Addition of Monosodium Glutamate on the Production of L-hydroxyproline
4. Conclusions
Supplementary Materials
Author Contributions
Funding
Institutional Review Board Statement
Informed Consent Statement
Data Availability Statement
Conflicts of Interest
References
- Hara, R.; Kino, K. Characterization of novel 2-oxoglutarate dependent dioxygenases converting l-proline to cis-4-hydroxy-l-proline. Biochem. Biophys. Res. Commun. 2009, 379, 882–886. [Google Scholar] [CrossRef] [PubMed]
- Zhang, Z.; Liu, P.; Su, W.; Zhang, H.; Xu, W.; Chu, X. Metabolic engineering strategy for synthetizing trans-4-hydroxy-L-proline in microorganisms. Microb. Cell Factories 2021, 20, 87. [Google Scholar] [CrossRef] [PubMed]
- Zhang, Z.; Su, W.; Bao, Y.; Huang, Q.; Ye, K.; Liu, P.; Chu, X. Modular reconstruction and optimization of the trans-4-hydroxy-L-proline synthesis pathway in Escherichia coli. Microb. Cell Factories 2022, 21, 159. [Google Scholar] [CrossRef] [PubMed]
- Hoa, B.T.M.; Hibi, T.; Nasuno, R.; Matsuo, G.; Sasano, Y.; Takagi, H. Production of N-acetyl cis-4-hydroxy-L-proline by the yeast. N-acetyl-transferase Mpr1. J. Biosci. Bioeng. 2012, 114, 160–165. [Google Scholar]
- Deng, W.H.; Lu, Y.; Liao, R.Z. Computational insights into chemoselectivity of Trans-4-Hydroxy-L-Proline dehydratase HypD. J. Catal. 2024, 439, 115736. [Google Scholar] [CrossRef]
- Shin, J.W. Optical activity of trans-4-hydroxy-L-proline in sodium chloride solutions. Chem. Phys. Lett. 2024, 838, 141086. [Google Scholar] [CrossRef]
- Fichman, Y.; Gerdes, S.Y.; Kovács, H.; Szabados, L.; Zilberstein, A.; Csonka, L.N. Evolution of proline biosynthesis: Enzymology, bioinformatics, genetics, and transcriptional regulation. Biol. Rev. Camb. Philos. Soc. 2015, 90, 1065–1099. [Google Scholar] [CrossRef]
- Hu, S.; He, W.; Wu, G. Hydroxyproline in animal metabolism, nutrition, and cell signaling. Amino Acids 2022, 54, 513–528. [Google Scholar] [CrossRef]
- Vijay Kumar, A.; Rama Rao, K. trans-4-hydroxy-L-proline: A novel starting material for N-alkylpyrroles synthesis. Tetrahedron Lett. 2011, 52, 3237–3239. [Google Scholar] [CrossRef]
- Campbell, A.C.; Bogner, A.N.; Mao, Y.; Becker, D.F.; Tanner, J.J. Structural analysis of prolines and hydroxyprolines binding to the L-glutamate-γ-semialdehyde dehydrogenase active site of bifunctional proline utilization A. Arch Biochem. Biophys. 2021, 698, 108727. [Google Scholar] [CrossRef]
- Shibasaki, T.; Mori, H.; Ozaki, A. Enzymatic production of trans-4-hydroxy-L-proline by region and stereospe-cific hydroxylation of L-proline. Biosci. Biotechnol. Biochem. 2000, 64, 746–750. [Google Scholar] [CrossRef] [PubMed]
- Liu, J.; Liu, M.; Shi, T.; Sun, G.; Gao, N.; Zhao, X.; Guo, X.; Ni, X.; Yuan, Q.; Feng, J.; et al. CRISPR-assisted rational flux-tuning and arrayed CRISPRi screening of an L-proline exporter for L-proline hyperproduction. Nat. Commun. 2022, 13, 891. [Google Scholar] [CrossRef] [PubMed]
- Liu, X.C. Hydrolysing the soluble protein secreted by Escherichia coli in trans-4-hydroxy-Lproline fermentation increased dissolve oxygen to promote high-level trans-4-hydroxy-Lproline production. Bioengineered 2019, 10, 52–58. [Google Scholar] [CrossRef] [PubMed]
- Wang, X.-C.; Liu, J.; Zhao, J.; Ni, X.-M.; Zheng, P.; Guo, X.; Sun, C.-M.; Sun, J.-B.; Ma, Y.-H. Efficient production of trans-4-hydroxy-L-proline from glucose using a new trans-proline 4-hydroxylase in Escherichia coli. J. Biosci. Bioeng. 2018, 126, 470–477. [Google Scholar] [CrossRef]
- Long, M.; Xu, M.; Ma, Z.; Pan, X.; You, J.; Hu, M.; Shao, Y.; Yang, T.; Zhang, X.; Rao, Z. Significantly enhancing production of trans-4-hydroxy-L-proline by integrated system engineering in Escherichia coli. Sci. Adv. 2020, 6, eaba2383. [Google Scholar] [CrossRef]
- Zhang, Y.; Zhang, Y.; Shang, X.; Wang, B.; Hu, Q.; Liu, S.; Wen, T. Reconstruction of tricarboxylic acid cycle in Corynebacterium glutamicum with a genome-scale metabolic network model for trans-4-hydroxyproline production. Biotechnol. Bioeng. 2019, 116, 99–109. [Google Scholar] [CrossRef]
- Edit, A.; Hourton-Cabassa, C.; Erdei, L.; Szabados, L. Methods for Determination of Proline in Plants. Methods Mol. Biol. 2015, 639, 317–331. [Google Scholar]
- Zhang, H.L.; Zhang, C.; Pei, C.-H.; Han, M.N.; Xu, Z.-D.; Li, C.-H.; Li, W. Efficient production of trans-4-hydroxy-L-proline from glucose by metabolic engineering of recombinant Escherichia coli. Lett. Appl. Microbiol. 2018, 66, 400–408. [Google Scholar] [CrossRef]
- Han, K.; Lim, H.C.; Hong, J. Acetic acid formation in Escherichia coli fermentation. Biotechnol. Bioeng. 1992, 39, 663–671. [Google Scholar] [CrossRef]
- Wang, X.-M.; Han, M.-N.; Jiang, J.-P.; Fu, S.-Q.; Zhang, F.-H.; Du, J.; Zhang, H.-L.; Li, W. Isolation of a Bacillus cereus strain HBL-AI and its application for production of trans-4-hydroxy-L-proline. Lett. Appl. Microbiol. 2021, 72, 53–59. [Google Scholar] [CrossRef]
- Choi, Y.-S.; Im, M.K.; Lee, M.R.; Kim, C.S.; Lee, K.-H. Highly sensitive enclosed multilayer paper-based microfluidic sensor for quantifying proline in plants. Anal. Chim. Acta 2020, 1105, 169–177. [Google Scholar] [CrossRef] [PubMed]
- Chen, G.; Strevett, K.A. Impact of carbon and nitrogen conditions on E. coli surface thermodynamics. Colloids Surf. B: Biointerfaces 2003, 28, 135–146. [Google Scholar] [CrossRef]
- Chen, X.; Yi, J.; Song, W.; Liu, J.; Luo, Q.; Liu, L. Chassis engineering of Escherichia coli for trans-4-hydroxy-L-proline production. Microb. Biotechnol. 2021, 14, 392–402. [Google Scholar] [CrossRef]
- Chen, X.; Yi, J.; Liu, J.; Luo, Q.; Liu, L. Enzymatic production of trans-4-hydroxy-L-proline by proline 4-hydroxylase. Microb. Biotechnol. 2021, 14, 479–487. [Google Scholar] [CrossRef]
- White, C.E.; Gavina, J.M.A.; Morton, R.; Britz-McKibbin, P.; Finan, T.M. Control of hydroxyproline catabolism in Sinorhizobium meliloti. Mol. Microbiol. 2012, 85, 1133–1147. [Google Scholar] [CrossRef]
- Brandenburg, F.; Theodosiou, E.; Bertelmann, C.; Grund, M.; Klähn, S.; Schmid, A.; Krömer, J.O. Trans-4-hydroxy-L-proline production by the cyanobacterium Synechocystis sp. PCC 6803. Metab. Eng. Commun. 2021, 12, e00155. [Google Scholar]
- Moradi, B.; Faramarzi, A.; Ghasemi-Esmailabad, S.; Aghaz, F.; Hashemian, A.H.; Khazaei, M. L-proline as a novel additive to cryopreservation media improved post-thaw quality of human spermatozoon via reducing oxidative stress. Andrologia 2022, 54, e14301. [Google Scholar] [CrossRef]
- Cheng, L.-K.; Wang, J.; Xu, Q.-Y.; Xie, X.-X.; Zhang, Y.-J.; Zhao, C.-G.; Chen, N. Effect of feeding strategy on L-tryptophan production by recombinant Escherichia coli. Ann. Microbiol. 2012, 62, 1625–1634. [Google Scholar] [CrossRef]
- Omori, K.; Suzuki, S.-I.; Imai, Y.; Komatsubara, S. Analysis of the Serratia marcescens proBA operon and feedback control of proline biosynthesis. J. Gen. Microbiol. 1991, 137, 509–517. [Google Scholar] [CrossRef][Green Version]
- Baneyx, F.; Mujacic, M. Recombinant protein folding and misfolding in Escherichia coli. Nat. Biotechnol. 2004, 22, 1399–1408. [Google Scholar] [CrossRef]
- Klein, C.; Hüttel, W. A simple procedure for selective Hydroxylation of L-proline and L-pipecolic acid with recombinantly expressed proline hydroxylases. Adv. Synth. Catal. 2011, 353, 1375–1383. [Google Scholar] [CrossRef]
- Lizhi, Z.; Yue, M.; Kaihang, W.; Chen, T.; Huang, Y.; Liu, L.; Li, Y.; Sun, J.; Hu, Y.; Li, T.; et al. Omics-guided bacterial engineering of Escherichia coli ER2566 for recombinant protein expression. Appl. Microbiol. Biotechnol. 2023, 107, 853–865. [Google Scholar]
- Yi, Y.; Sheng, H.; Li, Z.; Ye, Q. Biosynthesis of trans-4-hydroxyproline by recombinant strains of Corynebacterium glutamicum and Escherichia coli. BMC Biotechnol. 2014, 14, 44. [Google Scholar] [CrossRef] [PubMed]

| Host/Plasmid | Relevant Features |
|---|---|
| E. coli BL21(DE3) | F-ompT hsdSB (rB- mB-) gal dcm (DE3) |
| E. coli DH5α | Clone host |
| pWFP 1 | Ampicillin resistance containing proline-4-hydroxylase gene, Glutamate kinase gene, glutamate dehydrogenase gene |
| pET28b | Kanamycin resistance |
| pRSFDuet-1 | Kanamycin resistance |
| Number | Factors | Level 1 | Level 2 | Level 3 |
|---|---|---|---|---|
| A | Glucose (g/L) | 10 | 12 | 14 |
| B | Peptone (g/L) | 15 | 18 | 21 |
| C | Dipotassium hydrogenphosphate (g/L) | 1 | 2 | 3 |
| D | Calcium chloride (g/L) | 0.015 | 0.03 | 0.045 |
| E | Ferrous sulfate (g/L) | 0.8 | 1.2 | 1.6 |
| F | Magnesium sulfate (g/L) | 1 | 1.5 | 2 |
| G | Vitamin C (mmol/L) | 2 | 4 | 6 |
| Number | Different Recombinant E. coli | Enzyme Activity in U/mg Wet Cell Weight |
|---|---|---|
| 1 | BL21/pET28b-p4h-proB-proA | 929.74 |
| 2 | BL21/pRSFDuet-1-p4h-proB-proA | 352.49 |
| 3 | T7E/pET28b-p4h-proB-proA | 140.36 |
| 4 | T7E/pRSFDuet-1-p4h-proB-proA | 1406.46 |
| 5 | Rosetta/pET28b-p4h-proB-proA | 250.13 |
| 6 | Rosetta/pRSFDuet-1-p4h-proB-proA | 385.54 |
| Number | A Glucose | B Peptone | C K2HPO4 | D CaCl2 | E FeSO4 | F MgSO4 | G VC | L-Hydroxyproline (mg/L) |
|---|---|---|---|---|---|---|---|---|
| 1 | 1 | 2 | 1 | 2 | 3 | 3 | 3 | 1067.88 |
| 2 | 3 | 2 | 3 | 1 | 2 | 2 | 1 | 1571.05 |
| 3 | 2 | 2 | 2 | 3 | 1 | 1 | 2 | 1191.69 |
| 4 | 1 | 3 | 3 | 3 | 2 | 1 | 3 | 1317.48 |
| 5 | 2 | 2 | 3 | 2 | 3 | 1 | 1 | 1334.32 |
| 6 | 3 | 1 | 2 | 1 | 3 | 1 | 3 | 819.27 |
| 7 | 3 | 3 | 2 | 2 | 1 | 3 | 1 | 1442.28 |
| 8 | 1 | 2 | 2 | 1 | 2 | 3 | 2 | 1170.89 |
| 9 | 2 | 1 | 1 | 3 | 2 | 3 | 1 | 959.92 |
| 10 | 3 | 2 | 1 | 3 | 1 | 2 | 3 | 1247.16 |
| 11 | 1 | 3 | 2 | 3 | 3 | 2 | 1 | 1265.98 |
| 12 | 3 | 1 | 3 | 3 | 3 | 3 | 2 | 1293.71 |
| 13 | 1 | 1 | 3 | 2 | 1 | 2 | 2 | 890.59 |
| 14 | 2 | 1 | 2 | 2 | 2 | 2 | 3 | 1142.17 |
| 15 | 2 | 3 | 1 | 1 | 3 | 2 | 2 | 1173.86 |
| 16 | 2 | 3 | 3 | 1 | 1 | 3 | 3 | 1433.37 |
| 17 | 3 | 3 | 1 | 2 | 2 | 1 | 2 | 1306.59 |
| 18 | 1 | 1 | 1 | 1 | 1 | 1 | 1 | 1059.96 |
| K1 | 6772.78 | 6165.62 | 6815.37 | 7228.40 | 7265.05 | 7029.31 | 7633.51 | |
| K2 | 7235.33 | 7582.99 | 7032.28 | 7183.83 | 7468.10 | 7290.81 | 7027.33 | |
| K3 | 7680.06 | 7939.56 | 7840.52 | 7275.94 | 6955.02 | 7368.05 | 7027.33 | |
| k1 | 1128.80 | 1027.60 | 1135.90 | 1204.73 | 1210.84 | 1171.55 | 1272.25 | |
| k2 | 1205.89 | 1263.83 | 1172.05 | 1197.31 | 1244.68 | 1215.14 | 1171.22 | |
| k3 | 1280.01 | 1323.26 | 1306.75 | 1212.66 | 1159.17 | 1228.01 | 1171.22 | |
| R | 151.21 | 295.66 | 170.85 | 15.35 | 85.51 | 56.46 | 101.03 | |
| Optimum level | 3 | 3 | 3 | 3 | 2 | 3 | 1 | |
| Optimal combination | A3B3C3D3E2F3G1 | |||||||
| Sodium Glutamate (mM) | 0 | 10 | 20 | 30 | 40 | 50 |
|---|---|---|---|---|---|---|
| L-hydroxyproline (mg/L) | 1777.21 | 1836.64 | 2001.06 | 2149.63 | 2189.25 | 2171.42 |
Disclaimer/Publisher’s Note: The statements, opinions and data contained in all publications are solely those of the individual author(s) and contributor(s) and not of MDPI and/or the editor(s). MDPI and/or the editor(s) disclaim responsibility for any injury to people or property resulting from any ideas, methods, instructions or products referred to in the content. |
© 2025 by the authors. Licensee MDPI, Basel, Switzerland. This article is an open access article distributed under the terms and conditions of the Creative Commons Attribution (CC BY) license (https://creativecommons.org/licenses/by/4.0/).
Share and Cite
Yang, X.; Li, X.; Wang, Y.; Liu, Y.; Wang, F.; Sun, N.; Ye, C. Construction of Trans-4-hydroxy-L-proline-producing Escherichia coli and Optimization of Fermentation Conditions. Fermentation 2025, 11, 54. https://doi.org/10.3390/fermentation11020054
Yang X, Li X, Wang Y, Liu Y, Wang F, Sun N, Ye C. Construction of Trans-4-hydroxy-L-proline-producing Escherichia coli and Optimization of Fermentation Conditions. Fermentation. 2025; 11(2):54. https://doi.org/10.3390/fermentation11020054
Chicago/Turabian StyleYang, Xinchao, Xinyu Li, Yuanxiu Wang, Yuehui Liu, Fang Wang, Naxin Sun, and Chunjiang Ye. 2025. "Construction of Trans-4-hydroxy-L-proline-producing Escherichia coli and Optimization of Fermentation Conditions" Fermentation 11, no. 2: 54. https://doi.org/10.3390/fermentation11020054
APA StyleYang, X., Li, X., Wang, Y., Liu, Y., Wang, F., Sun, N., & Ye, C. (2025). Construction of Trans-4-hydroxy-L-proline-producing Escherichia coli and Optimization of Fermentation Conditions. Fermentation, 11(2), 54. https://doi.org/10.3390/fermentation11020054
